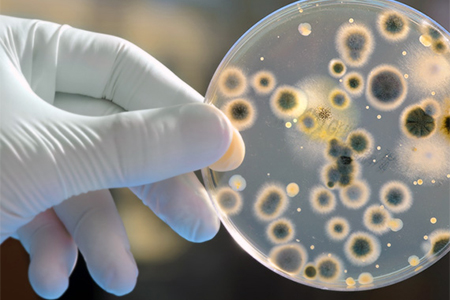

The scope of Biology services at Mavens encompasses comprehensive in vitro and in vivo profiling of molecules for their activity in various biochemical and cell-based systems and animal models.
Our facilities are designed to meet the most stringent requirements of both national and international regulatory agencies. Biology activities at Mavens are carried out in strict accordance with guidelines from regulatory bodies such as the Committee for the Purpose of Control and Supervision of Experiments on Animals (CPCSEA), Institutional Animal Ethics Committee (IAEC), Institutional Biosafety Committee (IBSC), and Atomic Energy Regulatory Board (AERB).